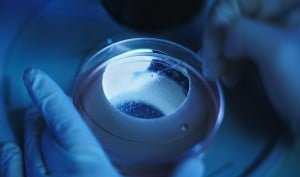
mice

Bilim adamları, robotlar için su itici, kendi kendini iyileştiren ve gerçekçi etli bir görünüme sahip “canlı” insan benzeri bir cilt icat etti.
İnsansı robotlar için canlı deri üretildi. BGR tarafından bildirildiği üzere Japon bilim adamları, insan derisine benzer şekilde çalışan bir “canlı deri eşdeğeri” oluşturmak için insan deri hücrelerini kullandılar. Laboratuarda yapılan cilt, gerçek insan derisinin görünümünü ve dokunuşunu başarıyla oluşturdu ve bu nedenle, canlı organizmalara çok benzer şekilde, suyu ittiği ve küçük yaralar ve sıyrıklarla yaralandığında kendini onardığı bulundu.

Araştırmacılar, bir cilt solüsyonu oluşturmak için kolajen ve insan dermal fibroblastlarını nasıl karıştırdıklarını açıkladıkları Matter dergisinde deneyle ilgili bir makale yayınladılar. Daha sonra robotik bir parmağı maddeye batırdılar ve malzemenin gerçek bir insan parmağı görünümü vermek için üç eklemli robotik vücut parçasına sıkıca uyduğuna tanık oldular.

Tokyo Üniversitesi’nde profesör olan ve bu çalışmanın baş yazarı olan Shoji Takeuchi, canlı cildin insansı robotlara gerçekçi bir görünüm kazandırmak için “nihai çözüm” olduğuna inanıyor çünkü deri replikasını oluşturmak için kullanılan malzeme aynı görsel dokuyu ve canlı organizmalar üzerinde deriden bekleyeceğimiz benzersiz yetenekleri geliştirdi.
İnsansı robotlar için canlı deri üretildi
Bilim adamları, özellikle sağlık ve hizmet sektörlerinde, insanların insansılarla etkileşimde kendilerini rahat hissetmelerini istiyor. İnsan benzeri bir görünümün robotları daha ulaşılabilir ve ilişkilendirilebilir kılmak için önemli bir faktör olduğunun farkındalar ve cildin ayrıntılarını daha da iyileştirmek için henüz saç köklerini, tırnakları ve ter bezlerini birleştirebileceklerini belirtiyorlar.

Robot teknolojisi artık bilim kurgu olmaktan çıkıp son yıllarda hızla ilerliyor. Elon Musk, bu yıl bir Tesla Bot prototipini ortaya çıkarmak için çalışırken Engineered Arts, Ameca adında gerçeğe yakın bir insansı robotu piyasaya sürdü, ancak herkes bunun hakkında nasıl hissedeceğini bilmiyordu, özellikle de HBO’nun Westworld’ünün bir bölümünü izlemiş olanlar.
Amazfit Band 7 için geri sayım başladı